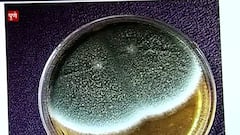
Pune : कोरोनानंतर मणक्याची बुरशी? पुण्यात 5 जणांच्या मणक्याला बुरशी संसर्ग? Special Report

एक्स्प्लोर
Tb
आरोग्य

Corona TB : कोरोनो झालेल्यांना Tuberculosis चा धोका? पाहा काय दिलाय केंद्रिय आरोग्य विभागानं सल्ला
News
Pune : कोरोनानंतर मणक्याची बुरशी? पुण्यात 5 जणांच्या मणक्याला बुरशी संसर्ग? Special Report
महाराष्ट्र

TB COVID-19: कोरोनाग्रस्तांना 'टीबी'चा धोका अधिक? ग्लोबल रुग्णालयाचे डॉ. हरीश चाफले यांच्याशी बातचीत
विश्व

World TB Day | आज जागतिक क्षयरोग दिवस, 2025 पर्यंत देशातून उच्चाटन करण्याचं आहे लक्ष
मुंबई

क्षयरोगावरील औषधांच्या पेटंटबाबत केंद्राने भूमिका स्पष्ट करावी : हायकोर्ट
Mumbai

Mumbai | शिवडीच्या टीबी रुग्णालयाच्या शौचालयात सापडला कुजलेल्या अवस्थेतील मृतदेह
Mumbai

शिवडीतील रुग्णालयाच्या शौचालयात सापडला कुजलेल्या अवस्थेतील मृतदेह, घटनेने खळबळ
India

टीबीमुळे गेल्या वर्षभरात 79 हजारांपेक्षा जास्त रुग्णांचा मृत्यू!
Advertisement
Advertisement




























